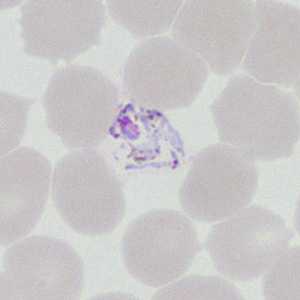
Case377_C
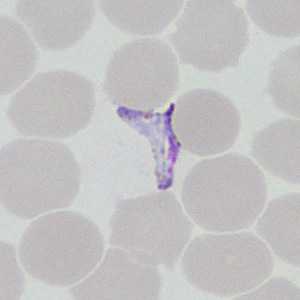
Case377_F

Case #377 - August 2014
A 22-year-old man had a post-travel medical evaluation that included hematologic work-up after returning from an 11-day missionary trip to Honduras. Blood was collected in EDTA at a medical center and thin smears were prepared and stained for examination. The stained smears were forwarded on to the State Public Health Laboratory for confirmation for diagnostic assistance. Digital images were captured at 1000x magnification with oil by the attending microbiologist at the PHL and submitted to the DPDx Team for a telediagnosis consult. Figures A-H show eight of images that were sent for analysis. What is your diagnosis? Based on what criteria?

Figure A

Figure B
Figure C

Figure D

Figure E
Figure F

Figure G

Figure H
Case Answer
This was a case of malaria caused by Plasmodium vivax. Diagnostic morphologic features included:
- rings with thick, sturdy cytoplasm (Figures A and E).
- large, very amoeboid trophozoites (Figures B and C) with fine, golden pigment.
- large, pleomorphic gametocytes (Figures F and H) with fine pigment
Figures D and G showed ookinetes. Ookinetes are motile zygotes formed by the combination of macrogametocytes and exflagellated microgametocytes in the mid-gut of the mosquito host. Ookinetes are not found in peripheral blood in the human host and are very rarely found on blood smears. Their presence on smears usually indicates a substantial delay occurred between the time the blood was collected and the time the slide was prepared. Their size and the way the pigment is distributed should be adequate to distinguish ookinetes from gametocytes of P. falciparum.
More on: malaria
Images presented in the monthly case studies are from specimens submitted for diagnosis or archiving. On rare occasions, clinical histories given may be partly fictitious.
DPDx is an education resource designed for health professionals and laboratory scientists. For an overview including prevention and control visit www.cdc.gov/parasites/.
- Page last reviewed: August 24, 2016
- Page last updated: August 24, 2016
- Content source:
- Global Health – Division of Parasitic Diseases and Malaria
- Notice: Linking to a non-federal site does not constitute an endorsement by HHS, CDC or any of its employees of the sponsors or the information and products presented on the site.
- Maintained By:


 ShareCompartir
ShareCompartir